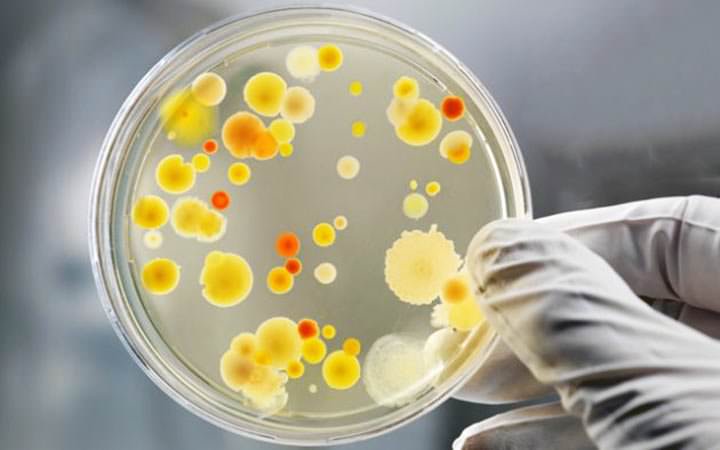
Crean antibiótico para bacterias súper resistentes

Científicos estadounidenses crean antibiótico para bacterias súper resistentes o también llamadas «superbacterias».
Los científicos añadieron tres modificaciones a la vancomicina (1) para que sea 1.000 veces más potente. El nuevo compuesto puede ser el arma eficaz contra la resistencia bacteriana.
Los científicos dieron ‘súper poderes’ a un antibiótico llamado vancomicina. El fármaco ha sido objeto de tres modificaciones que lograron el aumento de 1.000 veces la potencia de la droga.
Los científicos esperan que sea un arma eficaz como antibiótico para bacterias súper resistentes.
Los detalles del nuevo antibiótico fueron publicados en el último número de la revista Proceedings de la Academia Nacional de Ciencias (2).
Según los autores, el compuesto fue capaz de matar bacterias resistentes a los antibióticos conocidos. Causantes de infecciones urinarias, meningitis y endocarditis.
Super bacterias
El estudio fue realizado por el químico Dale Boger (2) del Instituto de Investigación Scripps en los Estados Unidos. Él utilizó la vancomicina para su fórmula única. Esta fórmula ha dado como resultado el más eficaz antibiótico contra bacterias súper resistentes.
Este medicamento se ha usado durante sesenta años y sólo recientemente se han reportado casos de bacterias resistentes a él.
El investigador, dice que las bacterias tuvieron un «trabajo duro» para superar el mecanismo de acción original del antibiótico.
Los estudios previos de Boger habían demostrado que era posible añadir dos cambios de fondo para que sea más potente.
El nuevo estudio describe una tercera modificación, que interfiere con la pared celular bacteriana en una forma sin precedentes. Esta aumenta 1.000 veces la actividad del fármaco. Esto significa que los médicos necesitan dosis mucho más bajas para combatir la infección.
La nueva versión de la vancomicina fue probada con éxito en bacterias del género Enterococcus.
Estas son responsables de la endocarditis, meningitis, infección del tracto urinario, entre otros.
Ella fue capaz de matar tanto las formas originales de estos microorganismos como las resistentes a la vancomicina común.
La innovación hace que el nuevo medicamento tenga tres mecanismos independientes de acción. Lo que significa que tiene una gran eficacia en la lucha contra las superbacterias.
«Los organismos simplemente no pueden encontrar una manera de superar los tres mecanismos. Incluso si las bacterias sobrepasan a uno de ellos, serían muertas por los otros dos». Dijo Boger en un comunicado.
La resistencia bacteriana
Ahora los investigadores quieren sintetizar vancomicina modificada utilizando un menor número de pasos en el laboratorio. Actualmente son treinta. Para Boger, esta es la parte más fácil del proyecto en comparación con el reto de diseñar el compuesto.
El investigador cree que el potencial de salvar vidas en esta nueva fórmula hace que su fabricación sea valiosa. Esto a pesar de las dificultades para su elaboración.
Según la Organización Mundial de la Salud (OMS), la resistencia bacteriana es una importante amenaza para la salud mundial.
Las principales enfermedades son cada vez más difíciles de tratar porque los antibióticos se vuelven menos eficaces. Por eso la importancia de hallar un antibiótico para bacterias súper resistentes.
Recursos externos:
(1) www.chemistryworld.com
(2)
https://youtu.be/KGZqtiZnk90
¿Qué te parece?